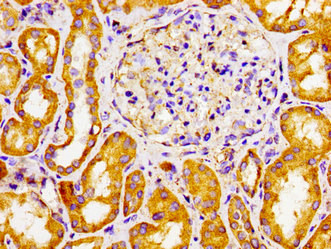

CYP27A1 Antibody
-
中文名稱:CYP27A1兔多克隆抗體
-
貨號:CSB-PA880560LA01HU
-
規格:¥440
-
圖片:
-
其他:
產品詳情
-
產品名稱:Rabbit anti-Homo sapiens (Human) CYP27A1 Polyclonal antibody
-
Uniprot No.:
-
基因名:
-
別名:12-alpha-triol 27-hydroxylase antibody; 5-beta-cholestane-3-alpha antibody; 5-beta-cholestane-3-alpha; 7-alpha; 12-alpha-triol 26-hydroxylase antibody; 5-beta-cholestane-3-alpha; 7-alpha; 12-alpha-triol 27-hydroxylase antibody; 5-beta-cholestane-3-alpha,7-alpha,12-alpha-triol 27-hydroxylase antibody; 7-alpha antibody; Cholestanetriol 26 monooxygenase antibody; CP27 antibody; CP27A_HUMAN antibody; CTX antibody; CYP antibody; CYP27 antibody; CYP27A1 antibody; Cytochrome P 450C27/25 antibody; Cytochrome P-450C27/25 antibody; Cytochrome P450 27 antibody; Cytochrome P450 27 mitochondrial antibody; Cytochrome P450 family 27 subfamily A member 1 antibody; Cytochrome P450 family 27 subfamily A polypeptide 1 antibody; Cytochrome P450 subfamily XXVIIA (steroid 27-hydroxylase cerebrotendinous xanthomatosis) polypeptide 1 antibody; mitochondrial antibody; Sterol 26 hydroxylase antibody; Sterol 26 hydroxylase mitochondrial antibody; Sterol 26-hydroxylase antibody; Sterol 27 hydroxylase antibody; Sterol 27-hydroxylase antibody; Vitamin D(3) 25 hydroxylase antibody; Vitamin D(3) 25-hydroxylase antibody
-
宿主:Rabbit
-
反應種屬:Human
-
免疫原:Recombinant Human Sterol 26-hydroxylase, mitochondrial protein (290-407AA)
-
免疫原種屬:Homo sapiens (Human)
-
標記方式:Non-conjugated
本頁面中的產品,CYP27A1 Antibody (CSB-PA880560LA01HU),的標記方式是Non-conjugated。對于CYP27A1 Antibody,我們還提供其他標記。見下表:
-
克隆類型:Polyclonal
-
抗體亞型:IgG
-
純化方式:>95%, Protein G purified
-
濃度:It differs from different batches. Please contact us to confirm it.
-
保存緩沖液:Preservative: 0.03% Proclin 300
Constituents: 50% Glycerol, 0.01M PBS, pH 7.4 -
產品提供形式:Liquid
-
應用范圍:ELISA, IHC
-
推薦稀釋比:
Application Recommended Dilution IHC 1:20-1:200 -
Protocols:
-
儲存條件:Upon receipt, store at -20°C or -80°C. Avoid repeated freeze.
-
貨期:Basically, we can dispatch the products out in 1-3 working days after receiving your orders. Delivery time maybe differs from different purchasing way or location, please kindly consult your local distributors for specific delivery time.
-
用途:For Research Use Only. Not for use in diagnostic or therapeutic procedures.
相關產品
靶點詳情
-
功能:Cytochrome P450 monooxygenase that catalyzes regio- and stereospecific hydroxylation of cholesterol and its derivatives. Hydroxylates (with R stereochemistry) the terminal methyl group of cholesterol side-chain in a three step reaction to yield at first a C26 alcohol, then a C26 aldehyde and finally a C26 acid. Regulates cholesterol homeostasis by catalyzing the conversion of excess cholesterol to bile acids via both the 'neutral' (classic) and the 'acid' (alternative) pathways. May also regulate cholesterol homeostasis via generation of active oxysterols, which act as ligands for NR1H2 and NR1H3 nuclear receptors, modulating the transcription of genes involved in lipid metabolism. Plays a role in cholestanol metabolism in the cerebellum. Similarly to cholesterol, hydroxylates cholestanol and may facilitate sterol diffusion through the blood-brain barrier to the systemic circulation for further degradation. Also hydroxylates retinal 7-ketocholesterol, a noxious oxysterol with pro-inflammatory and pro-apoptotic effects, and may play a role in its elimination from the retinal pigment epithelium. May play a redundant role in vitamin D biosynthesis. Catalyzes 25-hydroxylation of vitamin D3 that is required for its conversion to a functionally active form.
-
基因功能參考文獻:
- CYP27A1 SNPs are not associated with vitamin D status and multiple sclerosis. PMID: 30088172
- Vitamin D supplementation can decrease circulating 27HC of breast cancer patients, likely by CYP27A1 inhibition. This suggests a new and additional modality by which vitamin D can inhibit ER+ breast cancer growth, though a larger study is needed for verification. PMID: 29116467
- Whole-exome sequencing assuming recessive inheritance determined his genetic diagnosis to be cerebrotendinous xanthomatosis caused by homozygous mutations (c.410G>A or p.Arg137Gln) in the cytochrome P450 subfamily 27 A1 (CYP27A1) gene PMID: 29269672
- Three novel mutations in CYP27A1 were found in cerebrotendinous xanthomatosis patients in Chinese families PMID: 28623566
- Increased maternal and fetal cholesterol efflux capacity and placental CYP27A1 expression in preeclampsia PMID: 28396342
- Molecular study identified a novel homozygous frameshift mutation in CYP27A1 gene in cerebrotendinous xanthomatosis without cataract PMID: 28229379
- Cerebrotendinous xanthomatosis .. is caused by mutations in the CYP27A1 gene that result in decreased production of chenodeoxycholic acid (CDCA) and elevated levels of cholestanol and bile alcohols. Sequencing of CYP27A1 showed a paternally inherited splice mutation, c.446 + 1G>T, and a maternally inherited nonsense mutation, c.808C>T, predicting p.(Arg270*). PMID: 28590052
- we demonstrated the rare missense variant of CYP27A1 is associated with atopic dermatitis with elevated levels of total serum IgE. PMID: 27259383
- The 32 kb deleted region harbors the CYP2A7 gene and was enriched with enhancer, repressor and insulator sites. The wildtype allele was lost in the polyps of the proband PMID: 28306719
- CYP27A1 is a critical cellular cholesterol sensor in prostate cells and that dysregulation of the CYP27A1/27-hydroxycholesterol (27HC) axis contributes significantly to prostate cancer pathogenesis. PMID: 28130224
- CYP27A1 catalyzes hydroxylation of beta-sitosterol and ergosterol PMID: 26891232
- This study suggests a shared genetic etiology between MS and the characterized single-gene disorders, and highlights cholesterol metabolism and the synthesis of oxysterols as important biological mechanisms for familial MS PMID: 28337550
- CYP46A1 is involved in cholestanol removal from the brain and that several factors contribute to the preferential increase in cholestanol in the cerebellum arising from CYP27A1 deficiency. PMID: 28190002
- A significant decrease in the expression level of CYP27A1 in female patients could indicate their greater vulnerability to multiple sclerosis than the male patients. PMID: 27792005
- A novel mutation (c.1183_1184insT) in several members of a Colombian cerebrotendinous xanthomatosis family is responsible for mental retardation, psychiatric disorders, behavioral changes, and multiple domains cognitive impairment with dysexecutive dominance that progressed to early dementia. PMID: 26844446
- CYP27A1 belongs to the mitochondrial CYPs and plays a crucial role in the cholesterol homeostasis. PMID: 26638999
- Analysis of ~60,000 human exomes points to underdiagnosis of cerebrotendinous xanthomatosis due to CYP27A1 mutations. PMID: 26643207
- marinobufagenin is derived from bile acids and its biosynthesis is initiated by CYP27A1 enzyme PMID: 26374826
- The 25-hydroxylases CYP2R1 and CYP27A1 catalyze vitamin D to its circulating form 25-hydroxyvitamin D. PMID: 25845986
- In a patient with cerebrotendinous xanthomatosis, analysis of the CYP27A1 gene identified compound heterozygosity for p.A335V, a novel mutation. PMID: 25447658
- study describes two unrelated Sardinian families sharing the same CYP27A1 mutation, p.Arg479Cys; phenotype of the patients is characteristic of cerebrotendinous xanthomatosis PMID: 24584636
- The increased cutaneous CYP27B1 levels in the CKD patients suggest that the loss of renal activity of this enzyme is at least partially compensated for by the skin. PMID: 24029861
- Cyp27A1 mutations were identified in early onset CAD pedigree. PMID: 24080357
- Studied whether abnormal endometrial expression of CYP27A1 and/or CYP2R1 may impair VDR-antiproliferative properties in endometrial carcinoma. PMID: 24732451
- Data indicate that inhibition of CYP27A1 activity or knockdown and deletion of the Cyp27a1 gene induced adipocyte differentiation. PMID: 24280213
- The expression of CYP27A1 modulates the concentrations of active glucocorticoids in both humans and mice and in vitro. PMID: 24096962
- An alternative to elimination of brain cholesterol by the CYP46A1 mechanism is elimination by CYP27A1. PMID: 22185844
- This study has identified candidate genes for sporadic Amyotrophic lateral sclerosis( ALS), most notably CYP27A1. Mutations in CYP27A1 are causal to cerebrotendinous xanthomatosis which can present as a clinical mimic of ALS . PMID: 22509407
- study found that adenosine A2A receptor stimulation inhibited foam cell formation by a mechanism dependent on the expression of CYP27A1 PMID: 21258856
- Mutations consisting of c.1146_1151deletion-insertion and c.1214G>A substitution of CYP27A1 are identified in patients having cerebrotendinous xanthomatosis. PMID: 21958693
- CYP27A1 mutations were found in the proband and a Chinese family with Cerebrotendinous Xanthomatosis PMID: 22018287
- Sterol 27-hydroxylase cytochrome P450 27A1 (CYP27A1) is involved in elimination of 7-ketocholesterol from the retinal pigment epithelium. PMID: 21411718
- the post-translational modifications identified in CYP27A1 exemplify a general mechanism whereby oxidative stress and inflammation deleteriously affect protein function PMID: 21498512
- Four novel mutations located in different exons, in particular in the region of exons 2-5 of the CYP27A1 gene, present as classical cerebrotendinous xanthomatosis. PMID: 20402754
- The average P450 concentrations/mg of total tissue protein were 345 fmol of CYP46A1 and 110 fmol of CYP27A1 in the temporal lobe, and 60 fmol of CYP46A1 and 490 fmol of CYP27A1 in the retina. PMID: 21049985
- An Arg104Gln mutation in sterol 27-hydroxylase is identified in Japanese patients with cerebrotendinous xanthomatosis; case 1 is a compound heterozygote for Arg104Gln in exon 2 and Arg441Gln in exon 8. PMID: 20558929
- results indicate involvement of the JNK/c-jun pathway in AR-mediated upregulation of CYP27A1. The link to JNK signaling is interesting since inflammatory processes may upregulate CYP27A1 to clear cholesterol from peripheral tissues. PMID: 21134350
- down-regulation of genes involved in the cholesterol synthesis pathway results in down-regulation of CYP27A1 which diminishes oxysterol concentrations PMID: 20149624
- Overexpression of CYP27A1 in CHOP cells decreased progesterone conversion to 20alpha-DH-progesterone in a dose-dependent manner PMID: 19671838
- There needs to be a high level of suspicion of cerebrotendinous xanthomatosis (CXT) for any child with cataracts and developmental delay PMID: 20450308
- A Japanese patient with cerebrotendinous xanthomatosis has different mutations within two functional domains of CYP27. PMID: 11903362
- Endogenous CYP27A1 is of importance for the normal efflux of both cholesterol and cholestanol from tendons. PMID: 12117727
- levels of 27-hydroxycholesterol are not of critical importance for cholesterol homeostasis in mice. PMID: 12119285
- A compound heterozygous mutation in CYP27A1 (one missense mutation and one intronic nucleotide change) occurs in a Taiwanese family with cerebrotendinous xanthomatosis. PMID: 12242561
- The very high activity of CYP27A1 towards the cholestanol precursor 4-cholesten-3-one may be of importance in connection with the accumulation of cholestanol in patients with cerebrotendinous xanthomatosis PMID: 12777473
- The pathogenesis of cholesterolosis may be multifactorial, but is not caused by reduced efflux of cholesterol due to a defect sterol 27-hydroxylase mechanism. PMID: 14672608
- We reported a Hong Kong Chinese proband with Cerebrotendinous Xanthomatosis in which a novel acceptor splicing site mutation (IVS6-1G>T) was identified. PMID: 14741198
- nuclear receptor-regulated CYP27 expression is likely to be a key integrator of retinoic acid receptor-PPARgamma-LXR signaling, relying on natural ligands and contributing to lipid metabolism in macrophages PMID: 15340076
- stimulation of CYP27A1 by PPARgamma may represent a key previously unrecognized mechanism by which PPARgamma protects against atherosclerosis PMID: 15533057
- Data suggest that induction of sterol 27-hydroxylase (CYP27A1) by TGF-beta1 may be responsible for some of the anti-atherogenic properties of this cytokine. PMID: 15708352
顯示更多
收起更多
-
相關疾病:Cerebrotendinous xanthomatosis (CTX)
-
亞細胞定位:Mitochondrion inner membrane; Peripheral membrane protein.
-
蛋白家族:Cytochrome P450 family
-
組織特異性:Expressed in the neural retina and underlying retinal pigment epithelium (at protein level). Expressed in the gray and white matter of cerebellum (at protein level).
-
數據庫鏈接:
Most popular with customers
-
-
YWHAB Recombinant Monoclonal Antibody
Applications: ELISA, WB, IHC, IF, FC
Species Reactivity: Human, Mouse, Rat
-
Phospho-YAP1 (S127) Recombinant Monoclonal Antibody
Applications: ELISA, WB, IHC
Species Reactivity: Human
-
-
-
-
-